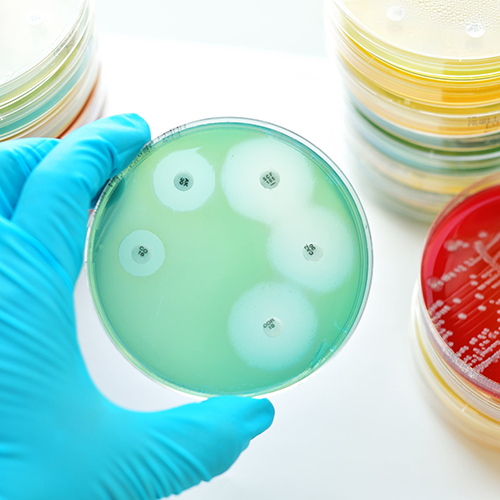

Pergunta clínica: Quais os fatores que influenciam a preferência dos utentes relativamente à prescrição imediata ou diferida de antibiótico?
Desenho do estudo: Estudo observacional transversal, através de questionário online, realizado no Reino Unido entre novembro de 2018 e fevereiro de 2019. Foi selecionada uma amostra representativa que foi dividida em 2 grupos: adultos (n=802) e pais de crianças/ jovens com idade inferior a 18 anos (n=801). De seguida, foram apresentados 12 cenários (hipotéticos) de infeções respiratórias. Para cada cenário, os participantes tinham de escolher se preferiam a prescrição imediata de antibiótico ou a adoção de uma atitude expectante (na qual apenas iniciariam antibiótico em caso de agravamento sintomático ou ausência de melhoria no período pré-estabelecido).
Resultados: Os resultados dos 2 grupos de participantes foram similares. Os fatores que mais influenciaram as preferências relativas à antibioterapia foram o tipo de sintomatologia e, particularmente para os pais de crianças doentes, a duração do quadro clínico. Mais de metade dos participantes preferiu adotar uma atitude expectante (sem início imediato de antibiótico) perante sintomas respiratórios ligeiros (como tosse e rinorreia). Contudo, esta preferência diminuiu quando existiam febre ou adenopatias, bem como à medida que a duração dos sintomas aumentou. Os subgrupos de utentes com idade mais avançada, do sexo feminino, com maior conhecimento sobre antibióticos e sem utilização recente deste tipo de medicação apresentaram maior probabilidade de preferir a atitude expectante, em detrimento da prescrição imediata de antibiótico.
Comentário: Os resultados sugerem que uma parte considerável dos utentes se encontra recetiva para adotar uma atitude expectante perante sintomas respiratórios ligeiros. Contudo, tal não se verificou relativamente à tosse acompanhada de febre ou odinofagia associada a adenopatias, situações nas quais a maioria dos utentes preferiu a prescrição imediata de antibiótico. Este artigo identifica, assim, uma área passível de intervenção na área de Educação para a Saúde – na qual o médico de família tem um papel fundamental. Segundo uma revisão da Cochrane Library [1], a prescrição diferida de antibióticos reduz a utilização destes fármacos, sem aumentar do risco de complicações associadas às infeções respiratórias. De ressalvar que a população que respondeu a este estudo apresentava elevado nível de escolaridade, pelo que os resultados não se devem generalizar para outras populações. Em resumo, na ausência de critérios que justifiquem o início de antibioterapia, a adoção da estratégia “wait-and-see” permite reduzir a prescrição de antibióticos, de forma segura para o doente e com manutenção do seu nível satisfação.
Artigo original: PLOS Medicine
Por Maria Beatriz Morgado, USF Cova da Piedade
[1] Spurling GKP, Del Mar CB, Dooley L, Clark J, Askew DA. Delayed antibiotic prescriptions for respiratory infections. Cochrane Database of Systematic Reviews 2017, Issue 9. Art. No.: CD004417. DOI: 10.1002/14651858.CD004417.pub5. Accessed 31 December 2021.
